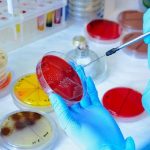

ASP I.S.P.E. – Istituto per i Servizi alla Persona per l’Europa cerca 21 infermieri
Concorso pubblico, per soli esami, per l’assunzione in servizio con contratto di lavoro a tempo indeterminato di n. 21 unità di personale nel profilo professionale di “infermiere”, area funzionari ed e.q. (ex d1), ccnl funzioni locali, di cui n. 19 a tempo pieno e n. 2 a tempo parziale a 18 ore/sett. – riapertura dei termini e modifica del bando.
Riapertura dei termini per la presentazione delle domande di ammissione al concorso pubblico per “Infermiere” indetta con determina del Direttore Amministrativo dell’ASP I.S.P.E. n. 64/2022 e resa nota con la pubblicazione in data 16.05.2022 del bando di selezione pubblica prot. n. 1102/2022;
- l’aumento del numero dei posti oggetto di selezione da n. 18 unità a tempo indeterminato e pieno a n. 21 unità a tempo indeterminato, di cui n. 19 a tempo pieno e n. 2 a tempo parziale a n. 18 ore settimanali;
- la modifica del bando di selezione pubblica prot. n. 1102/2022 come di seguito riportato sul bando in allegato (evidenziate in neretto), allo scopo di adeguarne il contenuto al nuovo sistema di classificazione del personale introdotto dal sopravvenuto CCNL Funzioni Locali del 16.11.2022 e al “Regolamento interno disciplinante le procedure di selezione del personale e le modalità per l’accesso al lavoro presso l’ASP I.S.P.E.” come recentemente modificato con delibera C.S. n. 24/2023;
PRECISA - che restano valide le domande di partecipazione alla selezione pubblica già pervenute nel periodo dal 16 maggio 2022, data di pubblicazione del bando prot. I.S.P.E. n. 1102/2022, al 23 maggio 2023, data di adozione del “Piano del fabbisogno di personale 2023-2025”, fatti salvi gli esiti del successivo esame preliminare delle domande medesime;
- che le modifiche apportate al bando non hanno carattere sostanziale e non incidono sulla par condicio dei candidati; esse, pertanto, si intendono note a tutti i partecipanti alla selezione con la pubblicazione del presente bando.
La presente selezione è finalizzata all’assunzione in servizio con contratto di lavoro a tempo indeterminato di n. 21 unità di personale da inquadrare nel profilo professionale di “Infermiere”, Area Funzionari ed Elevata Qualificazione del vigente CCNL del Comparto Funzioni Locali 2019/2021 del 16.11.2022 (ex cat. “D”, pos. ec. iniz. “D1” del CCNL del Comparto Funzioni Locali 2016/2018 del 21.05.2018).
È prevista l’assunzione di n. 19 unità di personale a tempo pieno (pari a 36 ore settimanali secondo il vigente CCNL citato) e di n. 2 unità di personale a tempo parziale per n. 18 ore settimanali.
Scade il 12 settembre 2023 alle ore 13.
Redazione NurseTimes
Allegato
Segui il nostro gruppo Telegram “Concorsi e avvisi per infermieri e Oss”

Lascia un commento